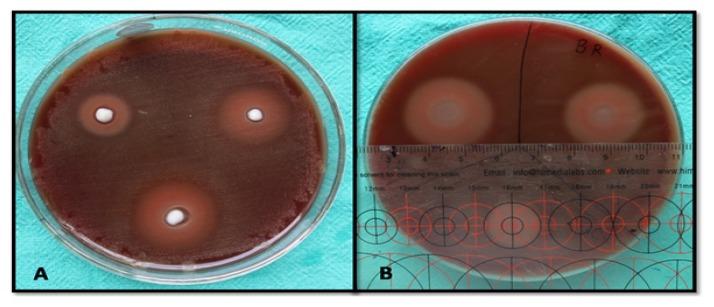
https://cdn.ncbi.nlm.nih.gov/pmc/blobs/18ba/6709969/088e97e21419/cm-92-288f2.jpg

三种不同玻璃离子水门汀对变形链球菌抗菌活性的评价:一项体外抗菌研究。
Evaluation of antibacterial activity of three different glass ionomer cements on streptococcus mutans: an in-vitro antimicrobial study.
作者信息
Khere Chhaya Harin, Hiremath Hemalatha, Sandesh N, Misar Pooja, Gorie Nishat
机构信息
Department of Conservative Dentistry and Endodontics, Sri Aurobindo College of Dentistry, Indore, India.
出版信息
Med Pharm Rep. 2019 Jul;92(3):288-293. doi: 10.15386/mpr-1113. Epub 2019 Jul 31.
AIM
Purpose of this in-vitro study was to assess and compare the antimicrobial activity of three different glass ionomer cements (GIC) against streptococcus mutans (S. mutans) bacteria using agar plate diffusion test.
METHODS
Thirty blood agar plates were prepared and three wells of 4mm diameter were made on each agar plate. Three different GIC (Micron bioactive, GC Fuji IX GP Extra, Bioglass r) were mixed and filled into the wells. These plates were inoculated with S. Mutans and incubated at 37°C for 24 hours. Bacterial growth inhibition zone around each well were recorded in millimeters using Hiantibiotic Zonescale-C.
RESULT
All the restorative material used in the study exhibited antimicrobial property against S. Mutans. GC Fuji IX GP Extra showed superior antimicrobial efficacy with 17.3±2.6 mm mean diameter of bacterial inhibition zone, followed by Micron bioactive 14.4±1.07 mm and Bioglass r 10.8 ± .91 mm inhibition zone respectively.
CONCLUSION
Within the limitation of this study, it can be concluded that all the GIC evaluated demonstrated antibacterial activity against S. mutans. The superior antimicrobial activity was demonstrated by GC Fuji IX GP Extra. Hence, it could be advantageous in patients with high caries risk.
目的
本体外研究的目的是使用琼脂平板扩散试验评估和比较三种不同玻璃离子水门汀(GIC)对变形链球菌的抗菌活性。
方法
制备30个血琼脂平板,每个琼脂平板上制作三个直径为4mm的孔。将三种不同的GIC(微米生物活性玻璃离子水门汀、GC Fuji IX GP Extra、生物活性玻璃r)混合并填充到孔中。这些平板接种变形链球菌并在37°C下孵育24小时。使用Hiantibiotic Zonescale-C以毫米为单位记录每个孔周围的细菌生长抑制区。
结果
研究中使用的所有修复材料均表现出对变形链球菌的抗菌性能。GC Fuji IX GP Extra显示出优异的抗菌效果,细菌抑制区平均直径为17.3±2.6mm,其次是微米生物活性玻璃离子水门汀14.4±1.07mm和生物活性玻璃r抑制区10.8±0.91mm。
结论
在本研究的局限性内,可以得出结论,所有评估的GIC均表现出对变形链球菌的抗菌活性。GC Fuji IX GP Extra表现出优异的抗菌活性。因此,它对高龋风险患者可能具有优势。